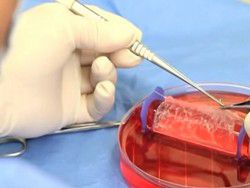

Специалисты изучают некоторые виды животных, которые могут жить достаточно долго. Если изучить все эти процессы, то можно замедлить старение.
Многие животные нашли способ избежать преждевременного старения. Например, гренландский кит, который живет в два раза дольше человека. Причем живут такие киты в дикой природе и не пользуются услугами врачей, к тому же долго не стареют. Но если откладывается старение, то можно отложить и разные заболевания.
Наши клетки восстанавливаются, но впоследствии разрушаются, поскольку они тоже производят отходы, а значит, их нужно чистить. Причем отходов с годами накапливается так много, что организм с этим не справляется. К тому же происходит деление клеток, которые становятся всё короче и короче, поэтому нарушается их функционирование. В результате организм стареет и становится уязвим для заболеваний.
Но существуют и некие тормоза, например, метформин, который замедляет старение у мышей. Причем безволосый землекоп живет до 30 лет в отличие от обычных мышей, которые живут два или три года. Это объясняется тем, что у землекопов клетки перестают расти, когда становятся достаточно плотными.
Возможно, это связано с химическим составом, в который входит гиалуроновая кислота. Вероятно, такая система и останавливает размножение клеток. То есть старость — это, в принципе, болезнь, которую можно вылечить.
Источник: podrobnosti.biz
